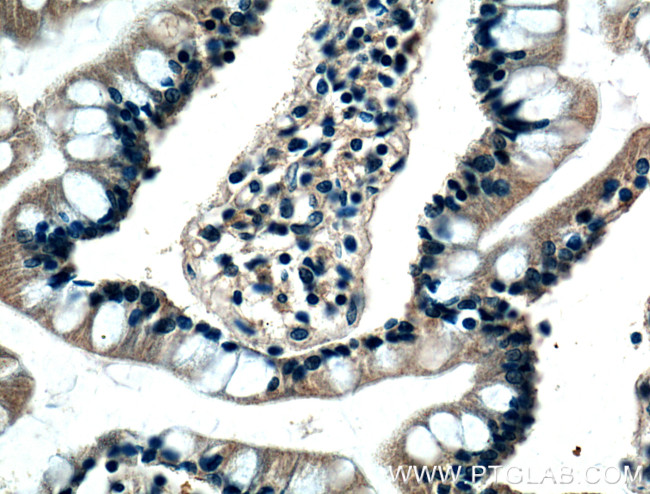
BMP2 Antibody in Immunohistochemistry (Paraffin) (IHC (P))

Search
Proteintech
BMP2 Monoclonal Antibody (1C5C2)
{{$productOrderCtrl.translations['antibody.pdp.commerceCard.promotion.promotions']}}
{{$productOrderCtrl.translations['antibody.pdp.commerceCard.promotion.viewpromo']}}
{{$productOrderCtrl.translations['antibody.pdp.commerceCard.promotion.promocode']}}: {{promo.promoCode}} {{promo.promoTitle}} {{promo.promoDescription}}. {{$productOrderCtrl.translations['antibody.pdp.commerceCard.promotion.learnmore']}}
产品信息
66383-1-IG
种属反应
宿主/亚型
分类
类型
克隆号
抗原
偶联物
形式
浓度
规格
纯化类型
保存液
内含物
保存条件
运输条件
产品详细信息
Immunogen sequence: MVAGTRCLL ALLLPQVLLG GAAGLVPELG RRKFAAASSG RPSSQPSDEV LSEFELRLLS MFGLKQRPTP SRDAVVPPYM LDLYRRHSGQ PGSPAPDHRL ERAASRANTV RSFHHEESLE ELPETSGKTT RRFFFNLSSI PTEEFITSAE LQVFREQMQD ALGNNSSFHH RINIYEIIKP ATANSKFPVT SLLDTRLVNQ NASRWESFDV TPAVMRWTAQ GHANHGFVVE VAHLEEKQGV SKRHVRISRS LHQDEHSWSQ IRPLLVTFGH DGKGHPLHKR EKRQAKHKQR KRLKSSCKRH PLYVDFSDVG WNDWIVAPPG YHAFYCHGEC PFPLADHLNS TNHAIVQTLV NSVNSKIPKA CCVPTELSAI SMLYLDENEK VVLKNYQDMV VEGCGCR (1-396 aa encoded by BC069214)
靶标信息
Bone Morphogenic Proteins (BMP) are members of the TGF-beta superfamily that affect bone and cartilage formation (Hogan 1996, Reddi 1998 and Francis-West et al. 1999). Mature BMPs are 30-38 kDa proteins that assume a TGF-beta -like cysteine knot configuration. Lovostatin increases bone formation by turning on the bmp-2 gene (Mundy et al. 1999). BMPs stimulate the production of specific bone matrix proteins and alter stromal cell and osteoclast proliferation (Macias et al. 1999, Lecanda et al. 1997). BMPs may also be an important factor for development of the viscera, with roles in cell proliferation, apoptosis, differentiation, and morphogenesis (Hogan 1996, Dale and Wardle 1999). BMPs appear to be responsible for normal dorsal/ventral patterning. Like TGF-beta, BMPs bind to a type II receptor, which then recruits the transducing type I receptor unit, activating the Smad protein signaling pathway (Massague 1994, Derynck 1997, Attisano 1993).
仅用于科研。不用于诊断过程。未经明确授权不得转售。
生物信息学
蛋白别名: 2610024H22Rik; AL117858; AW546137; BB189135; BMP; BMP-2; BMP-2A; BMPR-II; BMPRII; Bone morphogenetic; Bone morphogenetic protein; Bone morphogenetic protein 2; Bone morphogenetic protein 2A; H-BMP-2; morphogen; osteogenic protein 2
基因别名: BDA2; BMP2; BMP2A; SSFSC; SSFSC1
UniProt ID: (Human) P12643
Entrez Gene ID: (Human) 650, (Pig) 100157103